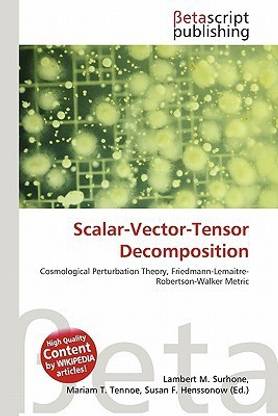
Scalar-Vector-Tensor Decomposition

Scalar-Vector-Tensor Decomposition (English, Paperback, unknown)
Price: Not Available
Currently Unavailable
Highlights
- Language: English
- Binding: Paperback
- Publisher: Betascript Publishing
- Genre: Science
- ISBN: 9786133021259, 9786133021259
- Pages: 86
Specifications
Book Details
| Imprint |
|
Dimensions
| Width |
|
| Height |
|
| Length |
|
| Weight |
|
Be the first to ask about this product
Safe and Secure Payments.Easy returns.100% Authentic products.
Back to top




